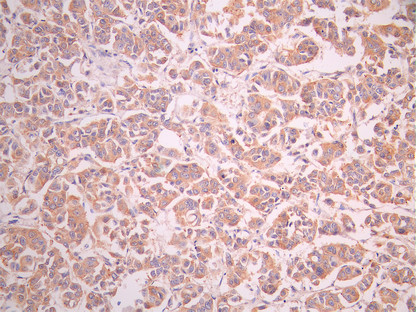

DAPK1 Recombinant Monoclonal Antibody
-
中文名稱:DAPK1 Recombinant Monoclonal Antibody
-
貨號:CSB-RA869286A0HU
-
規格:¥1320
-
圖片:
-
Western Blot
Positive WB detected in: COLO205 whole cell lysate(30μg), A431 whole cell lysate(30μg), A549 whole cell lysate(30μg)
All lanes:DAP antibody at 1:1000
Secondary
Goat polyclonal to rabbit IgG at 1/40000 dilution
Predicted band size: 160 kDa
Observed band size: 160 kDa
Exposure time:1min -
IHC image of CSB-RA869286A0HU diluted at 1:100 and staining in paraffin-embedded human lung tissue performed on a Leica BondTM system. After dewaxing and hydration, antigen retrieval was mediated by high pressure in a citrate buffer (pH 6.0). Section was blocked with 10% normal goat serum 30min at RT. Then primary antibody (1% BSA) was incubated at 4°C overnight. The primary is detected by a Goat anti-rabbit polymer IgG labeled by HRP and visualized using 0.05% DAB.
-
IHC image of CSB-RA869286A0HU diluted at 1:100 and staining in paraffin-embedded human breast cancer performed on a Leica BondTM system. After dewaxing and hydration, antigen retrieval was mediated by high pressure in a citrate buffer (pH 6.0). Section was blocked with 10% normal goat serum 30min at RT. Then primary antibody (1% BSA) was incubated at 4°C overnight. The primary is detected by a Goat anti-rabbit polymer IgG labeled by HRP and visualized using 0.05% DAB.
-
Overlay Peak curve showing 786-O cells stained with CSB-RA869286A0HU (red line) at 1:100. The cells were fixed in 4% formaldehyde and permeated by 0.2% TritonX-100 for 10min. Then 10% normal goat serum to block non-specific protein-protein interactions followed by the antibody (1ug/1*106cells) for 45min at 4℃. The secondary antibody used was FITC-conjugated goat anti-rabbit IgG (H+L) at 1/200 dilution for 35min at 4℃.Control antibody (green line) was Rabbit IgG (1ug/1*106cells) used under the same conditions. Acquisition of >10, 000 events was performed.
-
-
其他:
產品詳情
-
Uniprot No.:
-
基因名:
-
別名:DAK1 antibody; DAP K1 antibody; DAP kinase 1 antibody; DAPK 1 antibody; DAPK antibody; DAPK1 antibody; DAPK1_HUMAN antibody; Death Associated Protein Kinase 1 antibody; Death-associated protein kinase 1 antibody; DKFZp781I035 antibody
-
反應種屬:Human
-
免疫原:A synthesized peptide from human DAPK1 protein
-
免疫原種屬:Homo sapiens (Human)
-
標記方式:Non-conjugated
-
克隆類型:Monoclonal
-
抗體亞型:Rabbit IgG
-
純化方式:Affinity-chromatography
-
克隆號:8B3
-
濃度:It differs from different batches. Please contact us to confirm it.
-
保存緩沖液:Rabbit IgG in 10mM phosphate buffered saline , pH 7.4, 150mM sodium chloride, 0.05% BSA, 0.02% sodium azide and 50% glycerol.
-
產品提供形式:Liquid
-
應用范圍:ELISA, WB, IHC, FC
-
推薦稀釋比:
Application Recommended Dilution WB 1:500-1:5000 IHC 1:50-1:200 FC 1:50-1:200 -
Protocols:
-
儲存條件:Upon receipt, store at -20°C or -80°C. Avoid repeated freeze.
-
貨期:Basically, we can dispatch the products out in 1-3 working days after receiving your orders. Delivery time maybe differs from different purchasing way or location, please kindly consult your local distributors for specific delivery time.
-
用途:For Research Use Only. Not for use in diagnostic or therapeutic procedures.
相關產品
靶點詳情
-
功能:Calcium/calmodulin-dependent serine/threonine kinase involved in multiple cellular signaling pathways that trigger cell survival, apoptosis, and autophagy. Regulates both type I apoptotic and type II autophagic cell deaths signal, depending on the cellular setting. The former is caspase-dependent, while the latter is caspase-independent and is characterized by the accumulation of autophagic vesicles. Phosphorylates PIN1 resulting in inhibition of its catalytic activity, nuclear localization, and cellular function. Phosphorylates TPM1, enhancing stress fiber formation in endothelial cells. Phosphorylates STX1A and significantly decreases its binding to STXBP1. Phosphorylates PRKD1 and regulates JNK signaling by binding and activating PRKD1 under oxidative stress. Phosphorylates BECN1, reducing its interaction with BCL2 and BCL2L1 and promoting the induction of autophagy. Phosphorylates TSC2, disrupting the TSC1-TSC2 complex and stimulating mTORC1 activity in a growth factor-dependent pathway. Phosphorylates RPS6, MYL9 and DAPK3. Acts as a signaling amplifier of NMDA receptors at extrasynaptic sites for mediating brain damage in stroke. Cerebral ischemia recruits DAPK1 into the NMDA receptor complex and it phosphorylates GRINB at Ser-1303 inducing injurious Ca(2+) influx through NMDA receptor channels, resulting in an irreversible neuronal death. Required together with DAPK3 for phosphorylation of RPL13A upon interferon-gamma activation which is causing RPL13A involvement in transcript-selective translation inhibition.; Isoform 2 cannot induce apoptosis but can induce membrane blebbing.
-
基因功能參考文獻:
- DAPK1 methylation level is associated with gliomas clinical features and outcomes PMID: 29807777
- LncRNA MIR22HG could act as a tumor suppressor and inhibited EC cells proliferation through regulating miR-141-3p/DAPK1 axis. PMID: 29775889
- Our results showed that DAPK promoter methylation is tightly correlated with clinicopathological features of NSCLC and is associated with poor prognosis in patients. PMID: 29578152
- High Promoter Methylation of DAPK1 gene is associated with Breast Cancer. PMID: 29480000
- It is this DAPK1-NR2B interaction that arbitrates the pathological processes like apoptosis, necrosis, and autophagy of neuronal cells observed in stroke injury, hence we aimed to inhibit this vital interaction to prevent neuronal damage. PMID: 28858643
- DNA hypermethylation of DAPK1 gene promoter is a promising biomarker for OSCC prediction/prognostics PMID: 28412611
- Authors find that the LTP specificity of CaMKII synaptic accumulation is due to its LTD-specific suppression by calcineurin (CaN)-dependent DAPK1 activation, which in turn blocks CaMKII binding to GluN2B. PMID: 28614711
- rs4878104 T allele could significantly regulate increased DAPK1 expression in European population PMID: 28429084
- the DAPK-mTOR pathway is critical for anti-HCV effects of peg-IFN-alpha PMID: 27930338
- A significant correlation between changes in the levels of expression and methylation was detected for the three apoptosis-regulatory genes (APAF1, DAPK1, and BCL2). The results suggest that methylation play an important role in the regulation of the apoptosis system genes in breast cancer. PMID: 28429233
- Results show that DNA demethylation of distinct promoter regions is associated with re-expression of the tumor suppressor gene DAPK1. Its knockdown promotes tumor cell migration in breast cancer cell line. PMID: 28231808
- Data show that silencing DNA methyltransferase 1 (DNMT1) increased expression of tumor suppressor genes, RASSF1A and DAPK, in esophageal squamous cell carcinoma (ESCC) cells and ESCC xenograft in nude mice. PMID: 27286455
- The current study supports a relevant role for p15, p16, and DAPK hypermethylation in the genesis of the plasma cell neoplasm. DAPK hypermethylation also might be an important step in the progression from MGUS to MM. PMID: 27622827
- DAPK1 methylation is associated with the risk of gastrointestinal cancer. PMID: 28934284
- downregulation of HOXC9 releases its transcriptional inhibition of DAPK1, resulting in the activation of the DAPK1-Beclin1 pathway, which induces autophagy in glioblastoma cells PMID: 26582930
- findings evidence a positive correlation between SIRT1 and BCL6 expression increase in follicular lymphomas (FL) . SIRT1 methylation decreases in FL and diffuse large-B cell lymphomas (DLBCL)and this parallels the increase of KLF4, DAPK1 and SPG20 methylation PMID: 28324774
- results suggest that DAPK1 is an important prognostic marker and therapeutic target for bladder cancer and have identified possible therapeutic agents for future testing in bladder cancer models with low DAPK1 expression PMID: 28388658
- Study provides evidence that DAPK1 is a negative-feedback regulator of the RIG-I pathway. RIG-I-mediated antiviral signaling activates DAPK1 kinase activity and DAPK1 inactivates RIG-I RNA sensing by direct phosphorylation of RIG-I. PMID: 28132841
- Meta-analysis suggested that aberrant methylation of DAPK promoter was associated with head and neck squamous cell carcinoma. PMID: 28249042
- our study characterized DAPK1 as a novel transcriptional target of BRMS1. Transcriptional activation of DAPK1 might be another important mechanism accounting for the metastasis suppressive activity of BRMS1. PMID: 28339067
- in Alzheimer's disease (AD) brains, elevated DAPK1 levels showed co-relation with the increase of APP phosphorylation. Combined together, these results suggest that DAPK1 promotes the phosphorylation and amyloidogenic processing of APP, and that may serve a potential therapeutic target for AD. PMID: 27094130
- The result suggests that DAPK promoter methylation is significantly increased in bladder cancer patients compared to normal controls. DAPK promoter methylation could serve as a biomarker for bladder cancer detection and management. PMID: 27907054
- Down-regulation of mRNA expression was found in cases in which CASP8, TMS1 and DAPK were hypermethylated. PMID: 28361856
- A transcription factor complex consisting of ATF6 (an endoplasmic reticulum-resident factor) and C/EBP-beta is required for the IFN-gamma-induced expression of DAPK1 IFN-gamma-induced proteolytic processing of ATF6 and phosphorylation of C/EBP-beta are obligatory for the formation of this transcriptional complex PMID: 27590344
- the present study demonstrated that DAPK contributed to the Hcyinduced endothelial apoptosis via modulation of Bcl2/Bax expression levels and activation of caspase 3 PMID: 27633052
- DAPK seems to be a major player that influences the migratory capability of disseminating tumor cells and possibly affects the dynamic interface between pro- and anti-survival factors at the invasion front of colorectal cancer. PMID: 26405175
- The sensitivity was found to be 62% and 83% for DAPK1 and SOX1, respectively, when analyzed separately in the singleplex assay, but increased to 90% in the multiplex assay when either or both of the SOX1 and the DAPK1 gene promoters showed methylation. PMID: 27452040
- Authors observed the cleavage of ATF6, the phosphorylation of MRLC, and the expression of death-associated protein kinase (DAPK1) by western blotting; the transcription of DAPK1 by RT-PCR; and the subcellular localization of ATF6 and mAtg9 by immunofluorescence. PMID: 27085326
- testing for DNA methylations of MGMT plus DAPK1 genes holds some promise for high grade cervical disease screening PMID: 26823825
- DAPK-1 and MLH1 methylation correlated inversely in tumors in the middle-third of the stomach PMID: 26810771
- The frequency of DAPK methylation was significantly higher in lung cancer than in non-malignant lung tissues. PMID: 25848215
- Our meta-analysis results reveal that DAPK promoter methylation might be associated with tumor metastasis and poor prognosis in NSCLC patients, although no correlation with histological types and TNM stage in NSCLC patients were found. PMID: 26406950
- Results identified MGMT and DAPK1 as predictors of nodal metastasis in oral and oropharyngeal squamous cell carcinoma with a high predictive value and specificity and sensitivity. PMID: 26213212
- Viral infection induced DAPK1-IRF7 and DAPK1-IRF3 interactions and overexpression of DAPK1 enhanced virus-induced activation of the interferon-stimulated response element (ISRE) and IFN-beta promoters and the expression of the IFNB1 gene. PMID: 24531619
- DAPK1 is highly expressed in the peritumoral region of glioblastoma multiforme brain neoplasms. PMID: 26165472
- A significant strong association between DAPK1 promoter methylation and CC was shown and confirmed independently by histological tumor type, method used to evaluate methylation and source of control samples. PMID: 26267895
- miR-191-DAPK1 axis may play an important role modulating the response of ovarian endometriosis and endometrioid carcinoma cells to TNF-alpha. PMID: 26191186
- The authors discuss evidence suggesting potential contributions of DAPK in the regulation of gut inflammation and intestinal homeostasis. [review] PMID: 25963636
- Besides mediating the anticancer effect, pDAPK(S308) may serve as a predictive biomarker for Raf inhibitors combination therapy, suggesting an ideal preclinical model that is worthy of clinical translation. PMID: 26100670
- These data define a novel link between DAPK and HSF1 and highlight a positive-feedback loop in DAPK regulation under mild inflammatory stress conditions in colorectal tumors. PMID: 25380824
- high DAPK1 expression causes increased cancer cell growth and enhanced signaling via the mTOR/S6K pathway; evaluation of breast cancer patient data sets revealed that high DAPK1 expression associates with worse outcomes in women with p53-mutant cancers PMID: 26075823
- Hypermethylation and down-regulation of DAPk1 were closely related to lymph node metastasis, advanced tumor stage, and low survival rates in hypopharyngeal squamous cell carcinoma. PMID: 25496179
- DAPK1 gene over-expression can suppress the proliferation, migration, and invasion of carcinoma of pancreas BxPC-3 cell line PMID: 25550789
- DAPK1 methylation is associated with poor overall- and disease-specific survival in a large cohort of DLBCL patients uniformly treated with rituximab. PMID: 25229255
- DAPK1 promoter methylation may be a biomarker during cervical carcinogenesis that might serve as an early indication of cervical cancer. [Meta-analysis] PMID: 25268905
- deregulation of p16-associated, and MLH1-associated pathways, because of promoter hypermethylation, is associated with increased cancer cell migration, tumor invasiveness, and, thus, aggressive phenotype PMID: 23804521
- In conclusion, hepatitis B virus x protein induces autophagy via activating DAPK in a pathway related to Beclin 1, but not JNK. PMID: 24188325
- The results show that DAPK promoter hypermethylation and repressed expression of DAPK protein were more common in central neurocytoma than in oligodendroglioma. PMID: 24877104
- The presence of aberrant DAPK1 methylation in bone marrow significantly reduced progression-free survival following immunochemotherapy, independent of Follicular Lymphoma International Prognostic Index score. PMID: 24814955
- Study shows that DAPK1 expression is regulated by ASK1, in response to IFN gamma and aids in the execution of autophagy. PMID: 25135476
顯示更多
收起更多
-
亞細胞定位:[Isoform 1]: Cytoplasm. Cytoplasm, cytoskeleton. Note=Colocalizes with MAP1B in the microtubules and cortical actin fibers.; [Isoform 2]: Cytoplasm. Cytoplasm, cytoskeleton.
-
蛋白家族:Protein kinase superfamily, CAMK Ser/Thr protein kinase family, DAP kinase subfamily
-
組織特異性:Isoform 2 is expressed in normal intestinal tissue as well as in colorectal carcinomas.
-
數據庫鏈接:
Most popular with customers
-
-
YWHAB Recombinant Monoclonal Antibody
Applications: ELISA, WB, IHC, IF, FC
Species Reactivity: Human, Mouse, Rat
-
Phospho-YAP1 (S127) Recombinant Monoclonal Antibody
Applications: ELISA, WB, IHC
Species Reactivity: Human
-
-
-
-
-